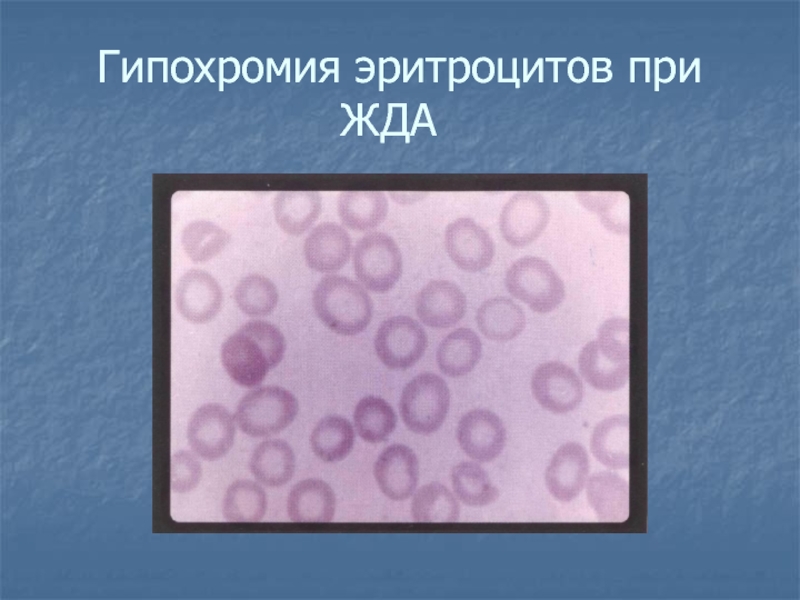
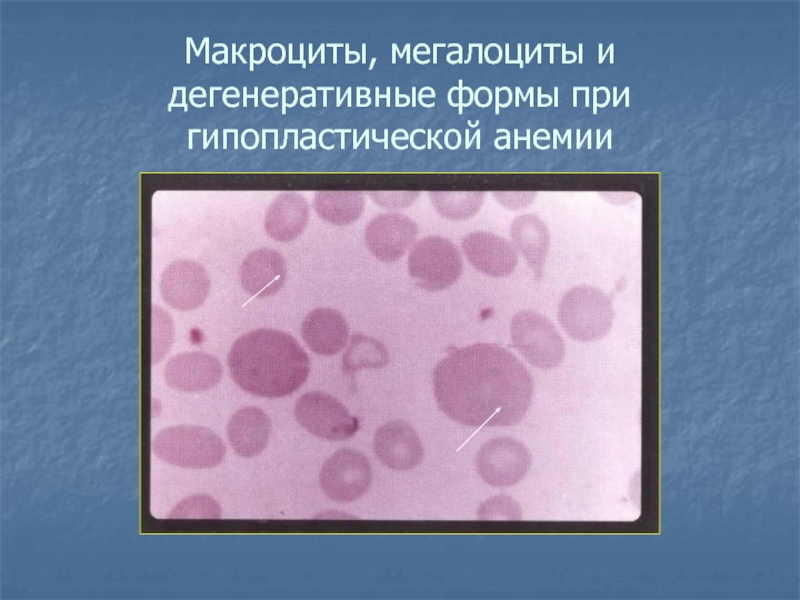
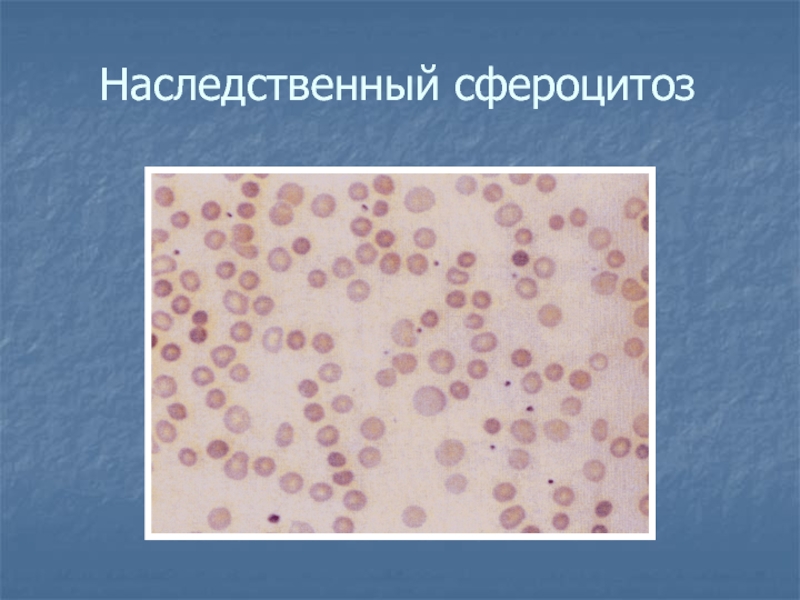

Слайд 1Патология системы крови.
Изменения количественного и качественного состава эритроцитов.
Слайд 2Вопросы к теме:
1. Этиопатогенез эритроцитозов.
2. Классификация анемий по патогенетическому
принципу.
3. Постгеморрагические анемии. Этиология, патогенез, гематологический синдром.
4. Дизэритропоэтические анемии.
- Железодефицитные анемии. Этиология, патогенез, гематологический синдром.
- Апластические анемии. Этиология Этиология, патогенез. Наследственные и приобретенные гемолитические анемии.
- В12 и фолиеводефицитные анемии. Этиология, патогенез, гематологический синдром.
- Анемии вследствие нарушения синтеза глобинов
5. Гемолитические анемии.
Слайд 3Тесты исходного уровня
Вариант 1
1 . Нормальные показатели Ht взрослого человека
1)
0,40–0,55
2) 0,45–0,65
3) 0,36–0,48
4) 0,32–0,52
Вариант 2
Наиболее информативными для постановки диагноза серповидно-клеточной
анемии являются
1) серповидной формы эритроциты
2) ретикулоцитоз
3) гипербилирубинемия
4) парапротеинемия
5) спленомегалия
Слайд 4Тесты исходного уровня
2. В первые минуты после острой кровопотери средней
тяжести возникает:
1) олигоцитемическая нормоволемия
2) нормоцитемическая гиповолемия
3) олигоцитемическая гиповолемия
4) полицитемическая гиповолемия
2. К концу первых-вторых суток после острой кровопотери средней тяжести наблюдается
1) полицитемическая гиповолемия
2) нормоцитемическая гиповолемия
3) олигоцитемическая нормоволемия
4) олигоцитемическая гиповолемия
5) олигоцитемическая гиперволемия
Слайд 5Тесты исходного уровня
3. Какой тип гипоксии развивается в организме в
первые минуты после массивной острой кровопотери
1) гемический
2) циркуляторный
3) тканевой
4) респираторный
3.
Какой тип гипоксии наблюдается в организме через 2-3 суток после острой кровопотери средней тяжести с успешным результатом проведенной терапии
1) смешанный (тканевой и циркуляторный)
2) тканевой
3) гемический
4) циркуляторный
Слайд 6Тесты исходного уровня
4. Интервал времени, в течении которого обычно восстанавливается
ОЦК (при потере 1000 мл) за счет поступления в сосуды
тканевой жидкости
1) 1–2 сут.
2) 2–3 сут.
3) 1–2 ч.
4) 4–5 сут.
4. Интервал времени, в течение которого обычно восстанавливается ОЦК (при потере 1000 мл) за счет активации эритропоэза
1) в течение 1–2 сут.
2)в течение 2–3 сут.
3) в течение 1–2 ч.
4) через 4–5 сут.
5) через 8–9 сут.
Слайд 7Тесты исходного уровня
5. Интервал времени, в течение которого обычно восстанавливается
белковый состав плазмы крови после острой кровопотери
1) 1–2 сут.
2) 3–4
сут.
3) 5–7 сут.
4) 8–10 сут.
5. Какая анемия возникает при дефиците внутреннего фактора
1) железодефицитная
2) энзимодефицитная
3) В12‑дефицитная
4) белководефицитная
Слайд 8Тесты исходного уровня
6. Каков ведущий механизм нарушений функций организма при
анемиях
1) полицитемическая гиповолемия
2) гемическая гипоксия
3) циркуляторная гипоксия
4) олигоцитемическая гиперволемия
6. Охарактеризуйте
состояние эритроцитарного ростка костного мозга при анемии, протекающей с содержанием HB равным 60 г/л и ретикулоцитов периферической крови, равным 0,9%:
1) регенераторное
2) арегенераторное
3) гипорегенераторное
4) гипопластическое
Слайд 9Тесты исходного уровня
7. Охарактеризуйте анемию, протекающую с отсутствием в костном
мозге эритробластов и в периферической крови ретикулоцитов
1) гипорегенераторная
2) гипопластическая
3) арегенераторная
4)
апластическая
7. С чем связано развитие анемии у новорожденных при RH-конфликте
1) с механическим повреждением эритроцитов
2) с кровопотерей
3) с иммунным повреждением эритроцитов
4) с нарушением эритропоэза
Слайд 10Тесты исходного уровня
8. Для гемолитической анемии характерна
1) олигоцитемическая гиповолемия
2) олигоцитемическая
гиперволемия
3) полицитемическая гиповолемия
4) олигоцитемическая нормоволемия
8. Какая из перечисленных анемий характеризуется
наибольшим содержанием эритропоэтинов
1) острая гемолитическая анемия
2) острая постгеморрагическая
3) хроническая постгеморрагическая
4) железодефицитная
Слайд 11Тесты исходного уровня
9. Внутрисосудистый гемолиз эритроцитов чаще возникает при
1) эритроцитопатиях
2)
переливании совместимой крови
3) при железодефицитной анемии
4) В12-дефицитной анемии
9. Основное
звено патогенеза первой стадии острой постгеморрагической анемии
1) повреждение сосудов
2) уменьшение ОЦК
3) дефицит железа
4) гипоксия гемического типа
Слайд 12Тесты исходного уровня
10. Железодефицитная анемия возникает при
1) дифиллоботриозе
2) спленомегалии
3) беременности
4)
вегетарианском питании
5) эритремии
10. Гиперхромная анемия связана с
1) дефицитом железа
2) дефицитом
фолиевой кислоты
3) болезнью Вакеза
4) острой кровопотетей
5) хроническими кровопотерями
Слайд 13Эталоны ответов
Вариант 1
1-3
2-2
3-2
4-1
5-4
6-2
7-4
8-4
9-1
10-3
Вариант 2
1-1
2-3
3-3
4-4
5-3
6-3
7-3
8-1
9-2
10-2
Слайд 16Первичный
(самостоятельные
формы)
Вторичный
(симптомы других
болезней)
1.Эритремия
(истинная полицитемия
болезнь Вакеза)
2. Наследственные
Абсолютные
2. Относительные:
гемоконцентрационные
(гиповолемические);
перераспределительные
Эритроцитоз
Слайд 17 Вторичные абсолютные эритроцитозы
Причина → ↑ образования эритропоэтина.
Наиболее часто к этому приводят:
Общая хроническая гипоксия любого генеза. Гипоксия стимулирует продукцию эритропоэтина → эритроцитоз обязательный симптом экзогенной и эндогенной гипоксии. При гипоксии эритроцитоз носит адаптивный характер.
Локальная ишемия почки (обеих почек), реже — печени, селезенки (при кистах, отеке, стенозе артерии).
Опухолевый рост, сопровождающийся продукцией эритропоэтина (новообразования почки, печени, селезенки).
Проявления в периферической крови: ↑ числа эритроцитов и их предшественников ретикулоцитов.
В отличие от эритремии, эритроцитозы обычно
не сопровождаются тромбоцитозом и лейкоцитозом!!
Слайд 18Вторичные относительные эритроцитозы
Характеризуются увеличением количества эритроцитов в единице объема крови
без активации их продукции в костном мозге и без повышения
их абсолютного числа в крови.
Наиболее частыми причинами развития являются:
1. Снижение объема плазмы крови (гемоконцентрация) при потере организмом жидкости (диарея, рвота, плазморрагия) → развитие полицитемической гиповолемии;
2. Выброс в циркулирующую кровь эритроцитов из депо (при стресс-реакции, острой гипоксии, гиперкатехоламинемии) с развитием полицитемической гиперволемии.
Слайд 20Анемия — уменьшение общего количества НЬ, что сопровождается снижением концентрации
НЬ в единице объёма крови (за исключением острой кровопотери).
Анемия
— всегда симптом какого-либо конкретного заболевания
Слайд 21Рука больного анемией и рука здорового человека
Слайд 22 Классификация анемии:
1.Происхождение: первичные (наследственные) и вторичные (приобретённые).
2.Патогенез: постгеморрагические, гемолитические и дизэритропоэтические.
3.Тип кроветворения: нормобластные и мегалобластные.
4.Регенераторная способность эритроидного ростка: регенераторные, гиперрегенераторные, гипорегенераторные, арегенераторные, апластические.
5.Размер эритроцитов: нормоцитарные, микроцитарные, макроцитарные, мегалоцитарные.
6.Цветовой показатель: нормохромные, гиперхромные, гипохромные.
7.Острота развития: острые и хронические
Слайд 23Ситуационная задача.
Пострадавший доставлен в больницу через 40 минут после огнестрельного ранения в живот. При поступлении: сознание спутано, кожные покровы бледные, дыхание учащенное поверхностное, пульс частый слабый. Артериальное давление - 65/35 мм рт. ст.
Анализ крови: гемоглобин - 148 г/л, эритроциты - 4,2x1012/л, цветовой показатель - 1,01. В связи с признаками внутреннего кровотечения и гемоперитонеума пострадавшему проведена перевязка поврежденной ветви артерии брыжейки.
В анализе крови, сделанном на четвертый день пребывания пострадавшего в клинике: гемоглобин - 68 г/л, эритроциты - 2,8x1012/л, ретикулоциты - 10%, артериальное давление -115/70 мм рт.ст.
Вопросы:
1. Оцените изменения и сделайте заключения по результатам анализов крови на первый и четвертый день после ранения пациента. В чем разница между ними?
2. Сохраняется ли патологическое состояние, имевшееся у пострадавшего при поступлении в клинику на четвертые сутки пребывания в ней?
3. Какие патологические явления развиваются в организме вследствие массивной кровопотери.
4. Какими компенсаторными механизмами организм отвечает на острую кровопотерю?
5. Цель трансфузионной терапии острой кровопотери?

Слайд 24Постгеморрагические анемии
развиваются в результате острого или хронического кровотечения
периоды
1.Рефлекторный
Количество
эритроцитов
и
Нв, цветной
показатель,
ретикулоциты
близко к норме
2.Гидремический
(1-2 суток)
эритропения.
цветной показатель и
ретикулоциты
около
нормы с
тенденцией к
снижению
3. Регенераторный
(костномозговой)
5-7 суток
цветной показатель
менее 1, Нв и
эритроциты уменьшены.
Полное восстановление
на 30-35 сутки
Слайд 25Хронические постгеморрагические анемии
Причины:
1.Длительные , повторяющиеся кровотечения в
результате нарушения целостности стенок сосудов(при инфильтрации в них опухолевых клеток,
экстрамедуллярном кроветворении, выраженной венозной гиперемии, язвенных процессах в ЖКТ, коже, слизистых оболочках)
2.Эндокринопатии и расстройства гомеостаза(при нарушении сосудистого, тромбоцитарного или коагуляционного механизмов у пациентов с геморрагическими диатезами)
Слайд 27Дизэритропоэтические анемии
В зависимости от происхождения:
Обусловленные нарушением эритропоэза в связи с
преимущественным повреждением стволовых клеток: гипо- и апластические анемии.
Обусловленные нарушением
эритропоэза в связи с преимущественным повреждением клеток-предшественников миелопоэза и/или эритропоэтинчувствительных клеток:
1. в результате нарушения синтеза гема (железодефицитные анемии);
2. вследствие нарушения синтеза нуклеиновых кислот эритроплазмоцитов (мегалобластические): витамин В12 — и/или фолиево-дефицитные анемии (болезнь Аддисона–Бирмера);
3. вследствие нарушения синтеза глобина: талассемии; серповидно-клеточная анемия.
Слайд 28Ситуационная задача
Ребенок В., 2 лет, родился недоношенным от 5
беременности (матери 25 лет), с 2-х недельного возраста находился на
искусственном вскармливании, часто болел простудными заболеваниями. У ребенка отмечается пониженный аппетит, сухость кожи. Ломкость ногтей, выпадение волос, ангулярный стоматит, склонность к употреблению штукатурки, угля, мела.
Анализ крови: гемоглобин - 60 г/л, эритроциты - 3,0х1012/л, ретикулоциты - 2,5% тромбоциты - 180х109/л.
Лейкоцитарная формула: миелоциты - 0, метамиелоциты - 0, П - 3, С - 49, Э - 2, Б - 0, Л - 39, М - 7, СОЭ - 18 мм/ч, выраженный анизоцитоз (микроциты), пойкилоцитоз умеренный; эритроциты с базофильной зернистостью.
Железо сыворотки - 5,1 мкмоль/л, непрямой билирубин - 12 мкмоль/л.
Вопросы:
1. Укажите, для какой формы анемии характерна данная гемограмма.
2. Этиология железо дефицитных анемий.
3. Картина крови.
4. Клинические признаки железодефицитных анемий.
5. Принципы лечения.
Слайд 29Обмен железа
Поступление(красное мясо, бобы, фасоль, салаты, шпинат)
Стабилизация Fe+++ желудочным соком
Восстановление
Fe+++ в Fe++ в двенадцатиперстной кишке(участвует В3 интегрин, мобилферритин, параферритин)
Перенос
в энтероцит при помощи белка транспортера
Кровь-Fe+++ связывается с трансферрином.
Железо запасов
Ферритин (комплекс Fe+++ и белка апоферритина)
Гемосидерин (фагоцитирующих макрофагах, паренхиматозных клетках)
Слайд 31Распространение дефицита железа
Треть населения земли имеет дефицит железа
2 млрд -
за счет недоедания
Женщины чаще мужчин. Дети, подростки, чаще взрослых.
Поступление и
всасывание
У мужчин-18мг с пищей, а всасывается 1-1,5мг.
Женщины-12-15мг, а всасывается 1,3мг.
Слайд 32Железодефицитные анемии
Этиология:
Дефицит железа в пище (алиментарный фактор).
Нарушение транспорта и всасывания
железа.
Повышенная потребность организма в железе (подростки и беременные).
Хронические кровопотери.
Слайд 33Стадии дефицита железа
1) Скрытый дефицит железа с повышенной абсорбцией в
кишечнике при нормальной картине крови.
2) Латентный дефицит железа с уменьшением
ферретина крови ,повышением протопорфирина в эритроцитах и снижение насыщения трансферрина железом
3) Устоявшийся дефицит железа. Гипохромная микроцитарная анемия
4) Выраженный дефицит железа. Гипорегенераторная анемия
Слайд 34Патогенез и симптомы железодефицитной анемии
Снижение содержание железа в сыворотки
крови, костном мозге, депо
Снижается синтез гемоглобина
Гипохромная анемия
Трофические расстройства в тканях
Сухость
и вялость кожи, ломкость ногтей, выпадение волос,
атрофия слизистой языка, извращение вкуса, мышечная слабость
Картина крови
Эритропения, сидеропения, гипохромия эритроцитов, микроцитоз,
пойкилоцитоз, анизоцитоз, лейкопения.
Слайд 36Железорефрактерные анемии
(нарушение включения железа в гем)
Слайд 39Ситуационная задача.
Больной К., 55 лет, поступил в
клинику с жалобами на повышенную утомляемость, сердцебиение, одышку, боли в
языке. Периодически возникает ощущение «ватных» ног, онемение конечностей. В последние годы отмечает упорные диспепсические расстройства.
Объективно: больной удовлетворительного питания, лицо одутловатое. Кожа, видимые слизистые, склеры желтушны.Температура тела -37,5°С. При осмотре ротовой полости язык воспален, сосочки атрофированы. На слизистой оболочке афты.
Гастроэнтерологическими обследованиями установлено резкое снижение желудочной секреции. При рентгеноскопии желудка выявлено нарушение эвакуаторной деятельности, уплощение и сглаженность складок. При фиброгастродуоденоскопии обнаружена атрофия слизистой желудка.
Общий анализ крови: эритроциты -1.8x1012/л, гемоглобин - 80г/л тромбоциты-130x109/л , гематокрита 0,25г/л, лейкоциты: 3.0x109/л,
СОЭ: 30 мм/л; лейкоцитарная формула: э.-0,б.-0, ю.-0, п.-3, с.-50, л.-40, м.-7. Содержание сывороточного железа:11.9 мкмоль/л.
Анизоцитоз +++, пойкилоцитоз +++, анизохромия +++.
Вопросы:
1.Дать обоснованное заключение о нарушении в системе крови.
2.Объяснить патогенез клинико-гематологических проявлений.
3.Чем отличается В 12-дефицитная анемия от анемии с недостатком фолиевой кислоты?

Слайд 40В12 - дефицитная анемия
Обмен витамина В12
Поступление с пищей животного происхождения
желудок-витамин
в12, связывается с R-протеином
в двенадцатиперстной кишке расщепление трипсином
витамин В12 в
щелочной среде, связывается с
внутренним фактором
Рецептор кубулин+комплекс кобаламин-внутренний фактор
Всасывание витамина В12
В крови связывается с транскобаламином
Слайд 41Две формы витамина В12
метилкобаламин
Фолиева кислота в тетрагидрофолиевую
Диоксиуридинмонофосфат
в деокситимидинмонофосфат
аденозинкобаламин
«работает» на сукцинил-коэнзим А, являющегося простетической
группой фермента метилмалонилкоэнзим
А мутазы-дефицит которого
ведет к накоплению метилмалоната и пропионата
избыток аномальных жирных кислот в липидах, входящих в состав
нервных структур
Предшественник ДНК
Деструкция нервной ткани
Слайд 42Причины мегалобластических анемий
1. Нарушение поступления витамина в организм (недостаток
витамина в пище, суровая вегетарианская диета);
2. Нарушение всасывания (дефицит внутреннего
фактора, пернициозная анемия, гастрэктомия, состояния мальабсорбции, патология подвздошной кишки, лимфомы, системный склероз, илеиты и резекция);
3. Избыточное поглощение витамина паразитами (дифиллоботриоз, избыточное размножение бактерий в слепых петлях и дивертикулах толстого кишечника);
4. Повышенное потребление витамина при беременности, гипертироидизме и диссеминированном раке.
5. Нарушение транспорта витамина В12, в силу наследственно-обусловленного отсутствия белка-транскобаламина.
6. Нарушение усвоения витамина В12 костным мозгом (метастазы рака в костный мозг, лейкозы, лучевая болезнь, нарушение усвоения витамина В12 эссенциальной природы).
Слайд 43Классическая триада
Мегалобластическая анемия
Глоссит Хантера
Фуникулярный миелоз
Картина крови
Макроцитарная, гиперхромная, гипорегенеративная, мегалобластическая, тельца
Жолли, кольца Кебота, макроцитоз, базофильная пунктация эритроцитов, лейкопения, гиперсегментированные нейтрофилы, тромбоцитопения
Лечение
Парентеральное введение витамина В12
Слайд 45Анемия Аддисона-Бирмера
Аутоиммунное заболевание
Антитела:
1 тип - блокирующие, блокируют связанный витамин В12
с внутренним фактором.
2 тип - нарушают связывание комплекса витамина В12-внутренний
фактор с его специфическим рецептором.
3 тип - против микроворсинок каналикулярной системы париетальных клеток.
Слайд 46Анемия Аддисона-Бирмера
Лабораторные признаки
Гиперхромная, макро-мегалоцитарная, гипо-арегенераторная.
Периферическая кровь
Макроцитоз, мегалоцитоз, гиперхромия эритроцитов, специфические
включения (телец Жолли, колец Кабо), пойкилоцитоз, лейкопения, тромбоцитопения, гиперсегментированные нейтрофилы
Костный
мозг
Появление очагов мегалобластическгого кроветворения «синий» костный мозг
Спинной мозг
Демиелинизация дорзального и латерального трактов, парезы, потеря чувствительности и парестезии.
Слайд 47Ситуационная задача.
Больная Р., 53 лет, поступила в клинику с
жалобами на прогрессирующую слабость, сердцебиение, одышку при физической нагрузке, головокружение,
снижение аппетита, боли и жжение в языке. При осмотре обращали на себя внимание выраженная бледность кожных покровов, иктеричность склер. Год назад больная перенесла резекцию тощей кишки. Анализ крови: Нв - 48 г/л, эритроциты - 1,2х1012/л, ретикулоциты - 0,1% тромбоциты - 96x109/л, лейкоциты - 3,9x109/л ,метамиелоциты - 0, П - 1, С - 44, Э - 2, Б - 0, Л - 49, М - 4, СОЭ - 27 мм/ч, В мазке крови: анизоцитоз, пойкилоцитоз, анизохромия, мегалоциты, единичные мегалобласты и полисегментированные нейтрофилы.
Железо сыворотки - 46 мкмоль/л, непрямой билирубин - 35 мкмоль/л. Осмотическая резистентность эритроцитов: мин. - 0,58%, макс. - 0,34% хлорида натрия.
Вопросы:
1.Укажите, для какой патологии системы крови характерна данная гемограмма?
2.Напишите развернутое обоснование вашего заключения.
3.Укажите какие системы страдают при данной патологии.
4.Принципы лечения данной патологии.
5.Роль внутреннего фактора для всасывания витамина В12.

Слайд 48Фолиеводефицитная анемия
Фолиевая кислота содержится в продуктах животного и растительного происхождения.
Всасывается в начальном отделе тощей кишки. Необходима в синтезе пиримидиновых
оснований, глутаминовой кислоты.
Этиология:
• Нарушение поступления фолатов в организм (алиментарного происхождения у детей, алкоголизм);
• Нарушение всасывания (состояния мальабсорбции, заболевания тонкого кишечника, резекция тощей кишки, где всасываются фолаты, антиконвульсанты и оральные контрацептивы);
• Повышенная потребность (беременность, детский возраст, диссеминированный рак);
• Блок использования фолатов лекарственными антагонистами (антиметаболитами);
• Целиакия (спру, глютенова энтеропатия, опухоли тонкого кишечника, лимфоматоз кишечника, хронические энтероколиты, сопровождающиеся упорной диареей).
Слайд 49Фолиеводефицитная анемия
Клиническая картина
Слабость, головокружение, боли в языке почти
не бывает, признаков фуникулярного миелоза не бывает
Картина крови
Характерна для дефицита
витамина В12, но эритроциты овальные
Лечение
Препараты фолиевой кислоты
Слайд 54Ситуационная задача.
Больная Б., 24 лет, поступила в отделение с
жалобами на слабость, повышенную утомляемость, одышку в покое, появление кровоподтеков
на теле, кровоточивость десен, боли при глотании. При осмотре отмечались бледность кожных покровов, множественные геморрагии, признаки язвенно-некротической ангины. Печень, селезенка и лимфатические узлы в паховой и подмышечной областях не увеличены.
Анализ крови: НЬ- 50г/л, эритроциты - 1,5х1012/л, ретикулоциты 0%, тромбоциты-28х109/л, лейкоциты-1,5х109/л, лейкоцитарная формула: миелоциты-0, метамиелоциты-0, п/я-1; с/я-18, э-0, лф-79, м-2. СОЭ-40мм/ч. В мазке крови: выраженный анизоцитоз и пойкилоцитоз; выраженная токсогенная зернистость эритроцитов. Железо сыворотки -41,8 мкмоль/л, билирубин-19 мкмоль/л.
При исследовании костного мозга выявлено уменьшение ядросодержащих клеток.
Вопросы:
Укажите, для какой патологии системы крови характерна данная гемограмма.
Виды анемий и их этиология;.
Патогенез гипо- и апластических анемий.
Оценить показатели гемо- и миелограммы.
Принципы лечения анемий.
Слайд 55
Гипопластическая и апластическая анемии
(развиваются в результате повреждения стволовых
клеток и подавления функции костного мозга)
Первичные
Анемия Фанкони - аутосомно-
рецессивное заболевание,
нарушение
репарации ДНК, аномалии скелета,
мягких тканей, почек, сердца.
Вторичные
Неясной этиологии, вызванные
хим. агентами (лекарства), облучение,
вирусная инфекция (гепатит).
виды
Слайд 56
Костно-мозговое кроветворение при гипо - и апластических анемиях:
• недостаток
клеток-эритроидных предшественников,
• сниженная чувствительность эритроцитарных клонов к эритропоэтину,
•
отсутствие атипизма клеток костного мозга,
• угнетение всех трех ростков гемопоэза,
• усиление апоптоза эритроидных клеток, усиление неэффективного эритропоэза.
Клетки костного мозга плохо утилизируют железо и слабо синтезируют ДНК. При этой патологии повышено сывороточное железо и нередким осложнением может стать гемосидероз органов.
Особенности периферической крови: нормохромная, нормоцитарная и гипо - или арегенераторная.
Принципы патогенетической терапии:
1. Пересадка костного мозга - наиболее эффективный метод.
2. Введение антилимфоцитарного глобулина и антитимического глобулина в сочетании с циклоспорином (при иммунозависимых формах).
3. Введение глюкокортикоидов и андрогенов (стимуляция гемопоэза).
4. Использование эритропоэтинов.
5. Применение колониестимулирующего фактора (лечение септических осложнений).
Слайд 58Макроциты, мегалоциты и дегенеративные формы при гипопластической анемии
Слайд 60Классификация гемолитических анемий
Слайд 61Ситуационная задача
Больной Л., 45 лет, поступил в клинику с
жалобами на головную боль, снижение памяти, плохой сон, боли в
конечностях, резкое снижение аппетита. Беспокоят эпизодически возникающие схваткообразные боли в животе, запоры.
Из анамнеза : последние 10 лет работает в кабельном производстве, имеет профессиональный контакт со свинцом. Мерами безопасности пренебрегает.
Объективно: больной пониженного питания. Кожа и видимые слизистые бледные с землисто-серым оттенком. Нистагм. Тремор пальцев рук. При осмотре ротовой полости - по краю десен у передних зубов -узкая лиловая полоса.
Общий анализ крови: эритроциты-2,1х1012/л, гемаглобин- 51 г/л, ЦП- 0,73, ретикулоциты 8%, лейкоциты- 3,8x109/л, тромбоциты- 140x109 /л, гематокрит 0,38л/л. Содержание сывороточного железа 91,5 мкмоль/л, СОЭ: 10мм/ч.
Примечание: Реакция мочи на b-аминолевулиновую кислоту резко положительна.
Вопросы:
Дать обоснованное заключение о нарушении в системе крови.
Объяснить этиологию и патогенез клинико-гематологических проявлений.
Дать развернутую классификацию данной патологии.
Как изменится объем крови? Типовые формы нарушения объема крови.
Принципы лечения данной патологии.

Слайд 63Ситуационная задача
Ребенок Б., 12 лет, поступил в клинику с жалобами
на боли в правом подреберье. Из анамнеза: родители фенотипически здоровы.
У отца при анализе крови в мазке - микроцитоз эритроцитов.
Объективно: у больного башенный квадратный череп, микроофтальмия. Мизинцы укорочены. При осмотре ротовой полости - высокое небо, неправильное расположение зубов. При абдоминальном УЗИ выявлены камни в желчном пузыре, спленомегалия.
Общий анализ крови: эритроциты - 3,5х1012/л, тромбоциты - 190х109/л, гемоглобин - 100 г/л, ЦП - 0,86, показатель гематокрита - 0,25, ретикулоциты - 5%, лейкоциты - 7,0x10 9/л, содержание сывороточного железа - 13,5 мкмоль/л, СОЭ - 17 мм/ч. Лейкоцитарная формула -Б-0, Э-2, нейтрофилы: Миэ-0, Ю-0, П-5, С-65, Л-24, М-4. Анизоцитоз (+++), микроцитоз, пойкилоцитоз (+++), сфероцитоз, анизохромия (++). Осмотическая резистентность эритроцитов снижена.
Вопросы:
1. Дать обоснованное заключение о нарушении в системе крови.
2. Напишите классификацию данной патологии.
3. Объяснить патогенез клинико-гематологических проявлений.
4. Патогенетические принципы лечения данной патологии.
5. Укажите характерный диагностический лабораторный признак этой анемии.

Слайд 64Наследственный сфероцитоз
БОЛЕЗНЬ МИНКОВСКОГО-ШОФФАРА
Аутосомно-доминантный тип наследования
Нарушение в структуре белков спектрина и
анкерина
Отпочковывание участка мембраны с образованием пузырьков
сфероцитоз
Замедление кровотока в селезенке и
разрушение
макрофагами сфероцитов
Клиника: внутриклеточный гемолиз, желтуха, увеличение селезенки,
анемия, камни в желчном пузыре, деформация скелета, особенно черепа.
Картина крови: микросфероцитоз, ретикулоцитоз
Слайд 66Овалоциты при гемолитической анемии
Слайд 67Механизм укорочения эритроцитов при микросфероцитарной анемии
Слайд 70Гемоглобинопатии
Это группа болезней, обусловленных заменой одной или
нескольких аминокислот в цепи глобина, отсутствием участка цепи или ее
удлинением.
Серповидноклеточная анемия - структурные нарушения глобина, в каждой бета-цепи в ее 6-ом положении глутаминовая аминокислота замещена на валин (точковая мутация). Гемоглобин А1, лишёный кислорода растворим вдвое меньше, чем гемоглобин А1, насышеный кислородом. Растворимость гемоглобина S при отдаче кислорода уменьшается в 100 раз - образуется гель. В условиях гипоксии этот гемоглобин кристаллизуется и выпадает в осадок в форме серпа - отсюда названии анемии «серповидноклеточная». Процесс образования геля и серповидных эритроцитов происходит не сразу, а с задержкой; большенство эритроцитов получают кислород и не становятся серповидными.
Слайд 71Патогенез серповидноклеточной анемии
Слайд 75Гематологические проявления талассемий
Слайд 76Дрепаноциты, мишеневидные эритроциты,
дакриоцит (дрепано-талассемия)
Слайд 78Большая -талассемия: в мазке обнаруживают гипохромный микроцитоз, мишенеподобные эритроциты, пойкилоциты
и ядросодержащие эритроциты. Некоторое количество нормальных эритроцитов – это клетки
перелитой донорской крови.
Слайд 79Энзимопатии
Наиболее часто обнаруживают следующие дефекты:
1.дефекты
активности ферментов гликолиза: пируваткиназы, гексокиназы, фосфофруктокиназы и др. В эритроцитах
ведущим путем ресинтеза АТФ является гликолиз. Следовательно, недостаток энергии АТФ обусловливает нарушение трансмембранного переноса ионов. Развивается их дисбаланс ► гипергидратация и набухание эритроцитов;
2.↓ активности энзимов пентозофосфатного цикла.
В ходе его реализации образуется восстановленная форма НАДФ, использующаяся для восстановления глютатиона. Восстановленный глютатион — компонент антиоксидантной системы эритроцитов
3.дефицит ферментов самой системы глютатиона (глютатионсинтетазы, глютатионредуктазы и т.д.).
Последствия активация липоперекисных реакций в эритроцитах, нарушения целостности их мембраны.
Пример: гемолитическая анемия, связанная с недостаточностью в эритроцитах Г-6-ФД. Гемолиз провоцируется приемом лекарственных препаратов (сульфаниламиды, антипиретики, анальгетики и др). При ↓ Г-6-ФД эритроциты быстро утрачивают минимум имеющегося восстановленного глутатиона и быстро стареют .

Слайд 80Энзимопатии
Анемия в следствии недостатка фермента
глюкозо-6 фосфатдегидрогеназы, аутосомный-рецессивный тип наследования
Прием лекарств
взаимодействие с оксигемоглобином
образование перекиси водорода
восстановленный
глютатион обезвреживает перекись и окисляется
для восстановления получает водород от НАДФ
участвует фермент глюкозо-6-фосфатдегидрогеназа
при его недостатке-окисление гемоглобина, выпадение в осадок цепей глобина
тельца Гейнца, селезенка освобождает эритроциты от телец Гейнца
гибель эритроцитов
гемолитический криз
Слайд 81Гемолитическая болезнь плода и новорожденных
Слайд 82 Практические навыки
Примеры типовых исследований системы
эритроцитов
Слайд 83Показатели
Гемоглобин 55г/л,
Эритроциты 3,6 × 1012/л,
цветовой показатель0,6,
ретикулоциты1,5%,
тромбоциты200 × 109/л,
Лейкоциты:
миелоциты-юные -0, палочкоядерные
2%,
сегментоядерные 64%,
эозинофилы 2%,
базофилы0%,
лимфоциты 27%,
моноциты 5%,
СОЭ16 мм/час
Примечание:
Анизоцитоз ++, железо сыворотки -5,2
мкмоль/л
Пойкилоцитоз ++
Показатели
Гемоглобин 80 г/л
Эритроциты 1,8 × 1012/л
Цветовой показатель 1,33
Ретикулоциты 1%
Тромбоциты 130 × 109/л
Лейкоциты 3,0 × 109/л
Миелоциты: юные 0
Палочкоядерные 1%
Сегментоядерные 40%
Эозинофилы-0
Базофилы-0
Лимфоциты 49%
Моноциты 10%
СОЭ 30 мм/час
Примечание: Эритроциты с тельцами Жолли, кольцами Кабо, базофильной пунктацией
Анизоцитоз ++
Пойкилоцитоз ++
Слайд 84Показатели
Гемоглобин 51.0 г/л
Эритроциты 2.1 × 1012/л
Цветовой показатель 0,73
Ретикулоциты 8 %
Тромбоциты
140 ×109/л
Лейкоциты 3.8 × 109/л
Миелоциты: юные-0
Палочкоядерные 1
Сегментоядерные 40
Эозинофилы 0
Базофилы 0
Лимфоциты
49
Моноциты 10
СОЭ 10
Примечание: Сывороточное железо 91,5 мкмоль/л
Анизоцитоз +++
Пойкилоцитоз +++ Антитела к эритроцитам.
Показатели
Гемоглобин 100 г/л
Эритроциты 3,5 × 1012/л
Цветовой показатель0,9
Ретикулоциты 14%
Тромбоциты 200 × 109/л
Лейкоциты 7× 109/л
Миелоциты: юные
Палочкоядерные 5%
Сегментоядерные 65%
Эозинофилы 2%
Базофилы-0
Лимфоциты 24%
Моноциты 4%
СОЭ 17 мм/час
Примечание: Сфероцитоз +++
Аниэоцитоэ +++ Осмотическая резистентность эритроцитов снижена
Пойкилоцитоз +++
Слайд 85Цель занятия
Рассмотреть основные сдвиги в периферической крови при экспериментальной (гемолитической)
анемии у кролика
Слайд 86Опыт
1.Экспериментальная гемолитическая анемия у кролика
Слайд 87
В течении недели предшествующей занятию, кролику трижды (с
двухдневным интервалом) вводят подкожно 3% раствор солянокислого фенилгидразина в разовой
дозе 0.6 мл. на 1 кг веса.
Слайд 88Перед забором крови ухо кролика необходимо тщательно разогреть!!!
Слайд 90
Из прокола краевой вены предварительно обработанного
эфиром уха кролика набирают в эритроцитарный меланжер кровь до метки
0,5 и разводят до метки 101 1% раствором хлористого натрия (разведение в 200 раз)
Слайд 92
В течение 2-3 минут меланжер встряхивают
Слайд 93
Затем 5-ю или 6-ю каплю смеси
из меланжера помещают под заранее притертое покровное стекло счетной камеры
Слайд 94
Эритроциты подсчитывают в 5 больших (т.
е. в 80 малых) квадратах сетки Горяева и вычисляют их
количество в 1 мм3 крови
Слайд 95Сетка Горяева и порядок передвижения сетки при подсчете эритроцитов
Слайд 96 Для вычисления пользуются формулой:
Э=(а х4000хв)/б
где: э – искомое
количество эритроцитов;
а – сумма эритроцитов, сосчитанных
в больших квадратах;
б –количество малых квадратов;
в-степень разведения крови (в 200 раз)
4000 – множитель, приводящий объем столбика жидкости в границах малого квадрата (1/4000 мм3) к 1 мм3.
Слайд 102Контрольный вопрос
Что характерно для гипо- и апластических анемий?
1. Сопровождаются лейкоцитозом
и тромбоцитозом.
2. Угнетение всех трех ростков гемопоэза.
3. Этиология- дефицит железа
в организме.
4. Патогенез- иммунологическая супрессия, аномалия в самих стволовых клетках.
5. Картина крови- гиперхромная, гиперрегенераторная, макроцитарная, мегалобластическая.
Слайд 103Тесты итогового уровня
Вариант 1
1. Главное звено патогенеза первой стадии острой
постгемморагической анемии
1) повреждение сосуда
2) уменьшение объема циркулирующей крови
3) гипоксия гемического
типа
4) дефицит железа
5) снижение содержания эритроцитов в крови
Вариант 2
1. Коннцентрация эритропоэтина в крови повышается при
1) любом абсолютном эритроцитозе
2) эритремии (болезнь Вакеза)
3) эритроцитозе вследствии гипоксии
4) любом относительном эритроцитозе
5) спленомегалии
Слайд 104Тесты итогового уровня
2. Для какой анемии характерен мегалобластический тип кроветворения
1)
α-талассемия
2) анемии, связанной с дефицитом железа
3) анемии, связанной с резекцией
подвздошной кишки
4) апластической анемии
5) серповидно-клеточной анемии
2. Для В12-(фолиево) - дефицитных анемий характерны следующие признаки
1) гипохромия эритроцитов
2) уменьшение содержания железа в сыворотке крови
3) положительный прямой тест Кумбса
4) наличие в крови эритроцитов с тельцами Жолли и кольцами Кебота
5) микросфероцитоз
Слайд 105Тесты итогового уровня
3. Наиболее частые причины железодефицитной анемии
1) недостаточное поступление
железа с пищей у детей
2) хроническая кровопотеря
3) беременность и лактация
4)
заболевания желудочно-кишечного тракта
5) все перечисленное
3. Усиление эритропоэза без повышения синтеза эритропоэтина возникает при
1) любом абсолютном эритроцитозе
2) эритремии (болезнь Вакеза)
3) эритроцитозе вследствии гипоксии
4) любом относительном эритроцитозе
5) гипернефроме (болезни Вильмса)
Слайд 106Тесты итогового уровня.
4. Опухолевую природу имеет
1) серповидно-клеточная анемия
2) эритремия (болезнь
Вакеза)
3) талассемия
4) железорефрактерная анемия
5) наследственная микросфероцитарная анемия
4. Первая стадия острой
постгеморрагической анемии называется
1) гидремическая
2) геморрагическая
3) рефлекторная
4) гипоксическая
5) фаза усиленного кроветворения
Слайд 107Тесты итогового уровня
5. Вторая стадия острой постгеморрагической анемии называется
1) гидремическая
2)
геморрагическая
3) рефлекторная
4) гипоксическая
5) фаза усиленного кроветворения
5. Третья стадия острой постгеморрагической
анемии называется
1) гидремическая
2) геморрагическая
3) рефлекторная
4) гипоксическая
5) фаза усиленного кроветворения
Слайд 108Тесты итогового уровня
6. Внутрисосудистый гемолиз характерен для
1) резус-конфликта
2) серповидно-клеточной анемии
3)
талассемии
4) наследственной микросфероцитарной анемии
5) верно всё перечисленное
6. Какую из перечисленных
анемий можно отнести к гипорегенераторным
1) хроническую постгеморрагическую анемию
2) острую постгеморрагическую анемию
3) гемолитическую анемию
4) наследственную микросфероцитарную анемию Минковского-Шоффара
5) серповидно-клеточную анемию
Слайд 109Тесты итогового уровня
7. Причина В12-дефицитной анемии
1) дефицит железа в организме
2)
повышение активности каллекреин – кининовой системы
3) отсутствие внутреннего фактора Кастла
4)
выработка антител к эритроцитам
5) длительно повторяющиеся кровотечения
7. Причина гипопластических анемий
1) резекция желудка
2) лейкозы
3) недостаток в пище витамина В12
4) гемолиз эритроцитов
5) УФ-облучение
Слайд 110Тесты итогового уровня
8. Наличие в периферической крови эритроцитов различной величины
называется
1) пойкилоцитоз
2) анизоцитоз
3) анизохромия
4) эритродиерез
5) сидероахрезия
8. Наличие в периферической крови
эритрорцитов различной формы называется
1) пойкилоцитоз
2) анизоцитоз
3) анизохромия
4) эритродиерез
5) сидероахрезия
Слайд 111Тесты итогового уровня
9. К анемии вследствие снижения синтеза эритроцитов относится
1)
анемия Аддисона-Бирмера (пернициозная)
2) талассемия
3) наследственная микросфероциторная анемия
4) эритремия (болезнь Вакеза)
5)
фавизм
9. Для злокачественной анемии Аддисона-Бирмера характерно
1) гипохромия эритроцитов
2) ретитулоцитоз
3) гиперхромия эритроцитов
4) микроцитоз эритроцитов
5) нормобластический тип кроветворения
Слайд 112Тесты итогового уровня
10. Возникновению гемолитической анемии может способствовать
1) повышение индекса
сферичности эритроцитов
2) понижение индекса сферичности эритроцитов
3) повышение осмотической и кислотной
резистентности эритроцитов
4) микроцитоз эритроцитов
5) увеличение содержание холестерина в мембране эритроцитов
10. Время жизни эритроцитов в крови резко сокращается при
1) железодефицитной анемии
2) наследственной микросфероцитарной анемии
3) В12-дефицитной анемии
4) острой постгеморрагической анемии
5) любом эритроцитозе
Слайд 113Эталоны ответов
Вариант 1
1-2
2-3
3-5
4-2
5-1
6-5
7-3
8-2
9-1
10-1
Вариант 2
1-3
2-4
3-2
4-3
5-5
6-1
7-2
8-1
9-3
10-2